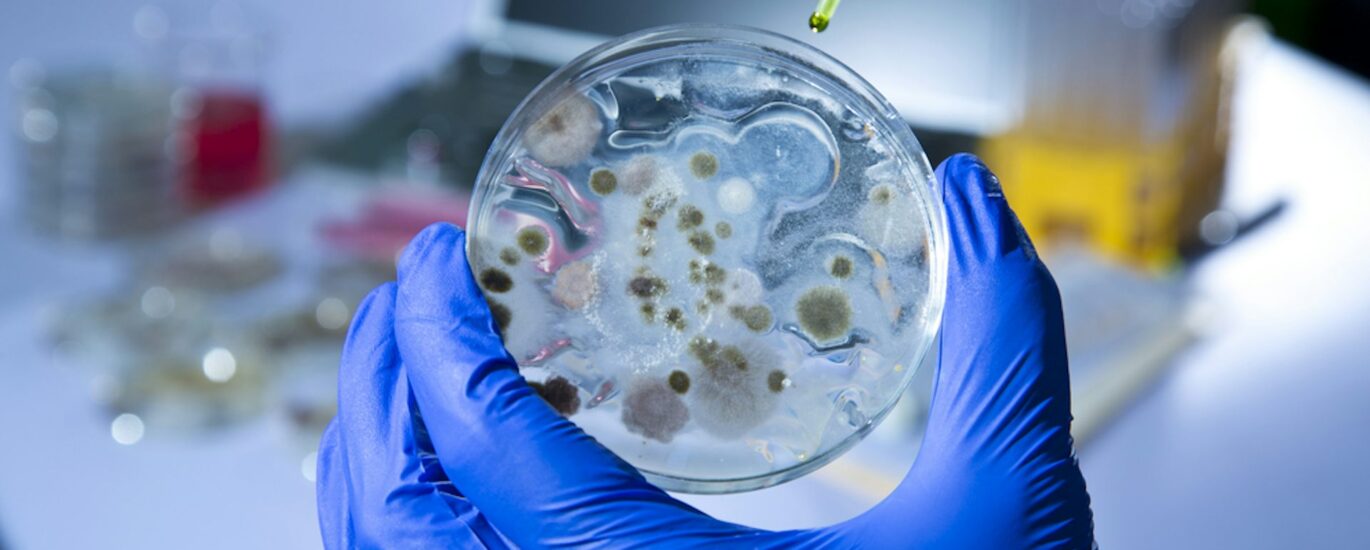
Microbial Identification Market

The global sales of microbial identification are estimated to be worth USD 4.69 billion in 2025 and anticipated to reach a value of USD 10.31 billion by 2035. Sales are projected to rise at a CAGR of 8.2% over the forecast period between 2025 and 2035. The revenue generated by microbial identification in 2024 was USD 4.33 billion.
The microbial identification market plays a critical role in healthcare, agriculture, food safety, environmental monitoring, and biotechnology. This market encompasses technologies and methods used to detect, identify, and classify microorganisms such as bacteria, fungi, viruses, and archaea. Accurate microbial identification is essential for diagnosing infections, ensuring food safety, and monitoring environmental health. Advances in molecular biology, genomics, and bioinformatics have propelled this market forward, enabling faster and more precise detection techniques compared to traditional methods.
Microbial identification helps in understanding microbial diversity and their interactions in various ecosystems, which is invaluable for scientific research and industrial applications. As the demand for rapid diagnostics grows, so does the need for innovative microbial identification solutions that offer reliability, speed, and cost-effectiveness. This market continues to evolve with advancements in sequencing technologies and data analysis tools, making it a dynamic and essential field in the life sciences sector.
Get Sample Report: – https://www.futuremarketinsights.com/reports/sample/rep-gb-5077
Market Trends
Emerging trends in the microbial identification market highlight the growing adoption of automated and high-throughput systems. Laboratories are increasingly shifting from culture-based techniques to molecular methods like polymerase chain reaction (PCR), matrix-assisted laser desorption ionization time-of-flight mass spectrometry (MALDI-TOF MS), and next-generation sequencing (NGS). These technologies provide faster turnaround times and greater accuracy, which is critical for clinical diagnostics and outbreak investigations.
Integration of artificial intelligence and machine learning in microbial identification is another notable trend. AI-driven algorithms enhance pattern recognition and data interpretation, enabling more precise identification even with complex microbial samples. Additionally, portable and point-of-care microbial identification devices are gaining traction, especially in resource-limited settings and field applications.
The market also witnesses increasing demand for multiplex assays that can detect multiple pathogens simultaneously. Such assays improve efficiency and reduce diagnostic costs, making them highly attractive for clinical and food safety laboratories. Sustainability and eco-friendly approaches are also influencing market trends, with a shift toward reducing reagent use and waste in microbial identification processes.
Driving Forces Behind Market Growth
Several factors contribute to the robust growth of the microbial identification market. The rising prevalence of infectious diseases worldwide underscores the need for rapid and accurate pathogen detection. Early identification of microbial agents allows for timely treatment, reducing morbidity and mortality rates. In addition, the increasing incidence of antibiotic-resistant bacteria fuels the demand for advanced microbial identification techniques that can guide targeted therapy and antimicrobial stewardship.
The expansion of the food and beverage industry further drives market growth. Ensuring food safety through the detection of harmful microbes is crucial to prevent outbreaks and maintain consumer confidence. Regulatory agencies worldwide are imposing stringent standards for microbial testing, compelling manufacturers to adopt advanced identification technologies.
Technological advancements also act as a significant growth driver. Innovations such as whole-genome sequencing provide comprehensive insights into microbial genomes, aiding in better pathogen characterization and epidemiological surveillance. Growing investments in research and development, coupled with increasing awareness about microbial contamination in various industries, contribute to expanding market opportunities.
The adoption of microbial identification tools in environmental monitoring is gaining importance as concerns about pollution and ecosystem health rise. Accurate identification of environmental microbes helps in assessing water quality, soil health, and the impact of contaminants. This broadening scope of applications fuels demand across diverse sectors.
Challenges and Opportunities
Despite promising growth prospects, the microbial identification market faces several challenges. High costs associated with advanced technologies and the need for skilled personnel can limit adoption, particularly in developing regions. Moreover, the complexity of microbial ecosystems and the presence of unknown or unculturable microorganisms pose difficulties in identification and interpretation.
Data management and bioinformatics remain critical hurdles. The vast amount of genomic and proteomic data generated requires sophisticated computational tools for analysis, which may not be readily accessible in all laboratories. Standardization of methodologies and validation of results across platforms also present ongoing challenges for market players.
However, these challenges pave the way for numerous opportunities. The development of user-friendly and cost-effective microbial identification platforms can open new markets, especially in emerging economies. Collaborations between technology providers, healthcare institutions, and regulatory bodies can accelerate the adoption of novel solutions.
The rise of personalized medicine offers an exciting opportunity for microbial identification technologies to tailor treatments based on individual microbiomes and pathogen profiles. Furthermore, integration with digital health platforms and telemedicine can expand the reach of microbial diagnostics beyond traditional laboratory settings.
Environmental and agricultural sectors also present untapped potential. Advanced microbial identification tools can aid sustainable farming practices, biofertilizer development, and monitoring of microbial populations critical for soil health. These diverse applications highlight the growing relevance of microbial identification technologies in addressing global challenges.
Recent Industry Developments
- The microbial identification market has witnessed notable developments in recent years. Several companies have launched innovative products that enhance speed and accuracy, such as next-generation sequencing platforms designed for clinical microbiology and food safety testing. These platforms offer comprehensive microbial profiling with minimal sample preparation.
- Collaborative initiatives between industry leaders and academic institutions have fostered breakthroughs in microbial genomics and metagenomics. These partnerships have accelerated the translation of research findings into commercial products and practical applications.
- The introduction of cloud-based bioinformatics solutions has revolutionized data analysis and sharing in microbial identification. Such platforms enable real-time collaboration among researchers and healthcare providers, improving response times during infectious disease outbreaks.
- Mergers and acquisitions remain a common strategy among top companies to consolidate market position and expand product portfolios. Investments in artificial intelligence and machine learning capabilities continue to reshape microbial identification workflows, offering enhanced predictive insights and decision support.
- Regulatory approvals and certifications for novel microbial identification assays have also increased, reflecting growing confidence in these technologies and paving the way for wider adoption across clinical and industrial sectors.
Regional Analysis
The microbial identification market exhibits significant regional variations driven by economic development, healthcare infrastructure, and regulatory environments. North America holds a dominant position due to advanced healthcare systems, strong R&D investments, and early adoption of cutting-edge technologies. The presence of major biotech hubs and supportive government initiatives further bolster market growth in this region.
Europe also represents a substantial market, fueled by stringent food safety regulations and a well-established pharmaceutical industry. Increasing focus on antimicrobial resistance surveillance and infection control programs drives demand for microbial identification solutions.
The Asia Pacific region is emerging as a high-growth market, driven by rapid industrialization, rising healthcare expenditures, and expanding food and agriculture sectors. Countries like China, India, and Japan are investing heavily in molecular diagnostics infrastructure, creating opportunities for market players.
Latin America and the Middle East & Africa exhibit moderate growth, with increasing awareness about infectious diseases and food safety concerns. However, challenges such as limited healthcare access and regulatory complexities may hinder rapid adoption. Strategic partnerships and government support could unlock the market potential in these regions.
Competitive Outlook
The microbial identification market is highly competitive, featuring a mix of established multinational corporations and innovative startups. Companies compete on product innovation, accuracy, speed, and cost-efficiency to capture market share. Continuous investment in research and development is a hallmark of leading players, enabling them to introduce novel technologies that meet evolving customer needs.
Strategic collaborations and partnerships help companies expand their geographical footprint and diversify product offerings. Many players focus on integrating microbial identification tools with complementary technologies like antimicrobial susceptibility testing and molecular diagnostics to provide comprehensive solutions.
Customer-centric approaches, including technical support, training, and customization, differentiate companies in this market. The ability to adapt to regulatory changes and demonstrate compliance with global standards is also crucial for competitive advantage.
The rise of digital health and data analytics presents new avenues for differentiation. Companies incorporating AI-driven analysis and cloud-based platforms are better positioned to address the demands of modern laboratories and healthcare providers.
Top Companies
Several companies stand out as leaders in the microbial identification market due to their extensive product portfolios and global reach. These companies invest heavily in innovation and maintain robust distribution networks to serve diverse customer segments.
Key players often offer a range of microbial identification solutions, including culture media, biochemical kits, molecular diagnostic platforms, mass spectrometry systems, and bioinformatics tools. Their commitment to quality and regulatory compliance helps build trust among clinical, food safety, and environmental customers.
These companies also engage in ongoing collaborations with academic and research institutions to drive technological advancements. Their focus on expanding into emerging markets supports long-term growth strategies.
The leadership of these companies is marked by their ability to balance innovation with affordability, ensuring that microbial identification technologies become accessible to a broad user base across various industries.
Explore In-Depth Analysis-Click Here to Access the Report:- https://www.futuremarketinsights.com/reports/microbial-identification-market
Segmentation Outlook
The microbial identification market can be segmented based on technology, application, end user, and geography. Technology segments include traditional culture-based methods, biochemical techniques, molecular methods, and advanced platforms such as MALDI-TOF MS and NGS.
Applications range from clinical diagnostics, food safety testing, environmental monitoring, pharmaceutical research, to agricultural biotechnology. Clinical microbiology dominates due to the critical need for pathogen identification in patient care, while food safety is rapidly gaining prominence driven by regulatory demands.
End users encompass hospitals, diagnostic laboratories, research institutes, food and beverage companies, and environmental agencies. Each segment has distinct requirements influencing the choice of microbial identification technologies.
Geographical segmentation highlights market disparities and growth opportunities across regions, reflecting varying healthcare infrastructures and industrial development levels. Understanding these segments helps companies tailor strategies and product offerings to meet specific market demands.
About Future Market Insights (FMI)
Future Market Insights, Inc. (ESOMAR certified, recipient of the Stevie Award, and a member of the Greater New York Chamber of Commerce) offers profound insights into the driving factors that are boosting demand in the market. FMI stands as the leading global provider of market intelligence, advisory services, consulting, and events for the Packaging, Food and Beverage, Consumer Technology, Healthcare, Industrial, and Chemicals markets. With a vast team of over 400 analysts worldwide, FMI provides global, regional, and local expertise on diverse domains and industry trends across more than 110 countries.
Contact Us:
Future Market Insights Inc.
Christiana Corporate, 200 Continental Drive,
Suite 401, Newark, Delaware – 19713, USA
T: +1-347-918-3531
For Sales Enquiries: sales@futuremarketinsights.com
Website: https://www.futuremarketinsights.com
LinkedIn| Twitter| Blogs | YouTube